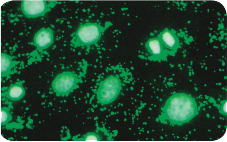
image.png

PRODUCT CLASSIFICATION
产品分类 更新时间:2026-01-31
更新时间:2026-01-31  浏览次数:8
浏览次数:8细胞生长缓慢?但培养基不浑浊、pH也没改变?
相比细菌、真菌造成的污染,细胞支原体污染经常被忽略。研究表明,有15%-35%的细胞培养受到支原体污染,在某些地区支原体污染甚至高达80%。
支原体直径小于1μm,可轻松穿过0.2μm的过滤膜,由于没有细胞壁,对青霉素等常规抗生素不敏感。细胞支原体感染,会抑制细胞生长、使DN段化、染色体畸变、阻断核酸合成、改变DNA转染效率等,严重时可导致细胞死亡。而且支原体污染很容易蔓延到整个细胞培养环境中,造成持续的危害。
MP支原体去除剂
·7天che底清除支原体
·低细胞毒
·预防细胞支原体感染复发
MP Biomedicals 支原体去除试剂Mycoplasma Removal Agent(MRA),主要成分为喹|啉家族的衍生物,通过抑制支原体DNA解旋酶清除支原体感染。
1、一次添加,7天见效
只需将MP支原体去除试剂一次添加到被污染的细胞中,孵育一周即可,相比其他品牌支原体去除剂,无需重复添加试剂,时间缩减50%以上,清除更高效。
2、清除che底,ECACC推荐
DNA解旋酶在微生物DNA复制中bi不可少,MP支原体去除试剂通过抑制解旋酶,能从被污染的培养细胞中che底清除支原体,被European Collection of Animal Cell Cultures 赞誉为去除支原体更有效的产品。
3、浓度低,范围广,无毒
MP支原体去除试剂0.5μg/mL即可达到清除支原体的作用,在工作浓度下使用几乎没有细胞毒,对常见的多种支原体株系均具有作用。
4、提前添加,防止复发
尚未被支原体污染的培养基,只需添加0.1μg/mL低浓度的MP支原体去除试剂,可有效预防支原体污染;清除支原体并更换培养基后,添加0.1μg/mL的MRA,可防止支原体污染再次复发。
5、细胞培养 提供更多保护
·原代细胞培养
·干细胞等珍贵细胞培养
·疫苗、抗体、重组蛋白、血清生产
·肿瘤细胞传代
MP支原体去除剂
货号:093050044
名称:Mycoplasma Removal Agent (MRA)
规格:5mL